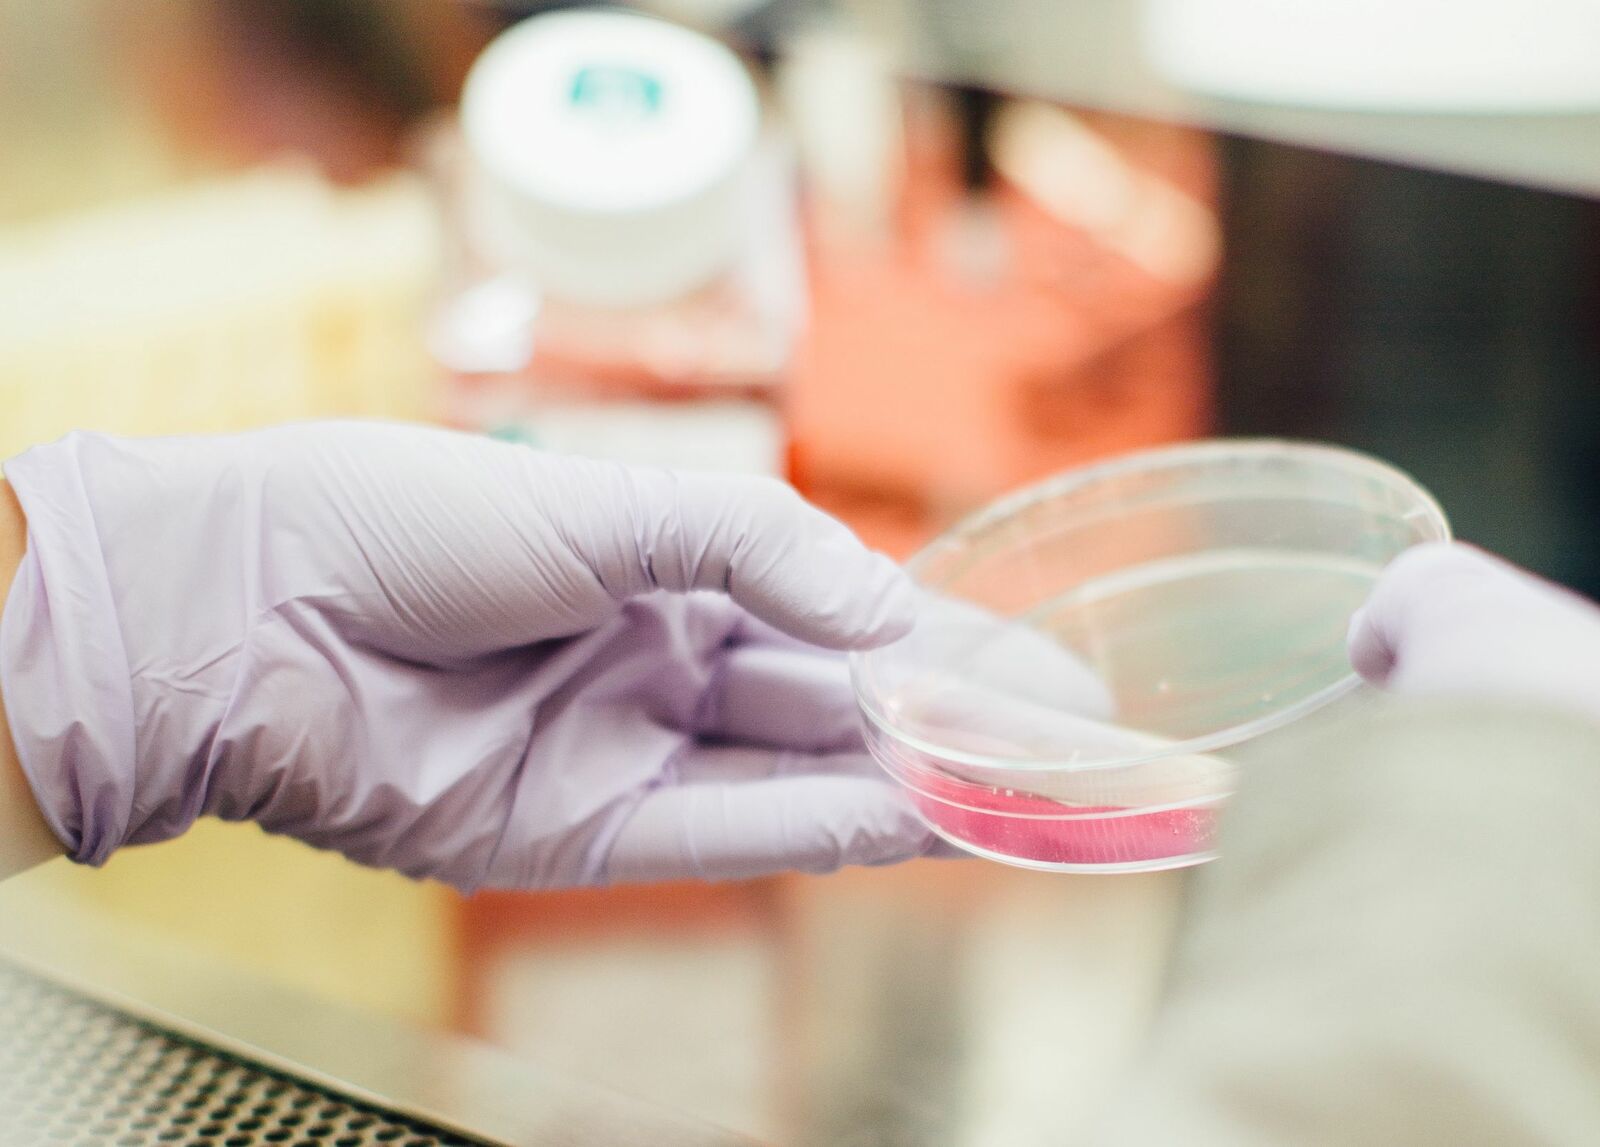
drew hays tGYrlchfObE unsplash

«Δεν θα παραμέναμε ζωντανοί για πολύ χωρίς τα μικρόβια», ισχυρίστηκε κάποτε ο Λουί Παστέρ. Λέτε να ήταν υπερβολικός;
Οι ειδικοί υποστηρίζουν πως παρά τους θεμελιώδεις και αμέτρητους ρόλους που διαδραματίζουν παντού οι μικροοργανισμοί, δεν μπορούμε να ισχυριστούμε ότι η ζωή δεν μπορεί να υπάρξει χωρίς αυτούς. Αλλά ακόμη και αν η ζωή συνέχιζε απουσία μικροβίων, τόσο η ποσότητα όσο και η ποιότητά της θα υποβαθμίζονταν δραστικά μαζί με τις συνθήκες στον πλανήτη.
Τέτοιες γενικεύσεις όμως είναι υπεραπλουστευμένες. Στην πράξη, η απουσία μικροοργανισμών, κυρίως των παθογόνων, μπορεί μεν να επεκτείνει τη διάρκεια ζωής, αλλά μεταβάλει αρνητικά τη φυσιολογία και την ανοσολογία των ζώων. Ζώα χωρίς μικροργανισμούς που ονομάζονται gnotobiotic (γνωτοβιοτικά) εμφανίζουν μειωμένη κινητικότητα στο έντερο που μπορεί να επιφέρει μέχρι και θανατηφόρες επιπλοκές, διαθέτουν μικρότερους λεμφαδένες και ανεπαρκώς ανεπτυγμένο ανοσοποιητικό σύστημα με μειωμένη ανοσοσφαιρίνη και λευκοκύτταρα ορού, ενώ παρουσιάζουν επίσης μειωμένα μεγέθη οργάνων.
Σε έναν κόσμο χωρίς βακτήρια και Αρχαία [(η επικράτεια (domain) της ζωής που βρίσκεται εξελικτικά μεταξύ των βακτηρίων και όλων των ευκαρυωτικών οργανισμών στη Γη], θα σταματούσαν οι περισσότεροι βιογεωχημικοί κύκλοι, θα συσσωρεύονταν γρήγορα ανθρώπινα και ζωικά απόβλητα και, εκτός από την εγγενή καταβολική ενζυματική δραστηριότητα, θα πραγματοποιείτο χαμηλού βαθμού αποσύνθεση. Ο ουσιαστικός ρόλος των μικροοργανισμών στην ανακύκλωση της βιομάζας δεν θα υποκαθίστατο από μύκητες ή από πρώτιστα, με αποτέλεσμα τα διαθέσιμα μακρο- και μικροθρεπτικά συστατικά σε χερσαία και υδάτινα περιβάλλοντα να εξαντλούνταν ταχύτατα. Θα ήταν όλο και πιο δύσκολο να βρεθούν ζωντανές πηγές τροφής, τα περισσότερα ζώα χωρίς μικροβιακούς συμβιώτες θα λιμοκτονούσαν και τα φυτά θα εξαντλούσαν γρήγορα το άζωτο, θα σταματούσαν τη φωτοσύνθεση και θα πέθαιναν.
Εάν συμπεριλάβουμε και τα μιτοχόνδρια και χλωροπλάστες (κυτταρικά οργανίδια) στα βακτήρια-σύμφωνα με τη θεωρία της ενδοσυμβίωσης-τότε η επίδραση θα ήταν πιο άμεση και οι περισσότεροι ευκαρυώτες θα ήταν νεκροί σε ένα λεπτό.
Ωστόσο, οι περισσότεροι μικροοργανισμοί δεν είναι εχθρικοί προς τους ζωντανούς οργανισμούς. Το αντίθετο μάλιστα, κατέχουν κομβικό ρόλο στη διατήρηση κάθε μορφής ζωής στον πλανήτη, συμπεριλαμβανομένης και της ανθρώπινης. Κάποια ζώα π.χ. χωρίς το κατάλληλο μικροβίωμα μπορεί να αρρωστήσουν ή και να πεθάνουν. Τα φυτά, επίσης, χρειάζονται μικροβιακούς εταίρους για να αναπτυχθούν. Θα έλεγε κάποιος πως οι μικροοργανισμοί είναι η «κόλλα» που συγκρατεί τα οικοσυστήματα ενωμένα, μεταφορικά και ενίοτε κυριολεκτικά, καθώς το έδαφος δημιουργεί συσσωματώματα εν μέρει λόγω της βλέννας που εκκρίνεται από αυτούς.
Πανταχού παρόντες οι μικροοργανισμοί
Εκτιμάται ότι στη Γη διαβιούν περίπου ένα τρισεκατομμύριο είδη βακτηρίων, μυκήτων, Αρχαίων και πρωτόζωων—οι ταξινομικές μορφές της ζωής που περιλαμβάνονται στον γενικό ορισμό των «μικροοργανισμών». Η θάλασσα είναι μια «σούπα» από μικροοργανισμούς και το χώμα μια θαυμαστή χώρα ενός ασύλληπτου τρόπου ζωής σε μικρογραφία. Ακόμα και o αέρας είναι «ζωντανός»! Εκατοντάδες εκατομμύρια ιοί και δεκάδες εκατομμύρια βακτήρια που κυκλοφορούν στον αέρα εναποτίθενται σε κάθε τετραγωνικό μέτρο της Γης κάθε μέρα. Στα θαλάσσια οικοσυστήματα, οι μικροοργανισμοί, κυρίως τα βακτήρια, αντιπροσωπεύουν περίπου το 70% της βιομάζας και είναι κρίσιμα για τον κύκλο των θαλάσσιων θρεπτικών συστατικών ενώ σε μόλις 20 σταγόνες νερό υπάρχουν 100.000 έως 1.000.000 βακτήρια, με τους ιούς να είναι από 10 έως 100 φορές περισσότεροι! Ακόμη και μικροσκοπικοί ιοί έχουν παγκόσμια βιομάζα 0,2 γιγατόνων άνθρακα, που αντιπροσωπεύει το 10% της βιομάζας όλων των ζώων.

wikimedia commons
Όμως, παρόλο που οι μικροοργανισμοί είναι πανταχού παρόντες, ορισμένες κοινότητές τους απειλούνται με εξαφάνιση για αυτό και έχουν αρχίσει να λαμβάνονται μέτρα. Για παράδειγμα, στο Εθνικό Πάρκο Yellowstone στις ΗΠΑ, απαγορεύεται η είσοδος των επισκεπτών σε πολλές από τις θερμές πηγές και τους θερμοπίδακες, για να προστατευθούν οι σπάνιες μικροβιακές κοινότητες που διαβιούν εκεί, ενώ δείγματα από μοναδικά μικροβιακά οικοσυστήματα σε υποπαγετώδεις απομονωμένες για εκατομμύρια χρόνια λίμνες της Ανταρκτικής λαμβάνονται προσεκτικά για να μην επιμολυνθούν με άλλους μικροργανισμούς.
Δυστυχώς, το κοινωνικοπολιτικό κίνημα διατήρησης της ισορροπίας της φύσης (conservation movement) δίνει ελάχιστη προσοχή στους μικροοργανισμούς. Απόδειξη είναι ότι την τελευταία δεκαετία, μόνο το 2% των ακαδημαϊκών εργασιών για τη διατήρηση των ειδών επικεντρώθηκαν σε αυτούς. Οι παγκόσμιες αξιολογήσεις της βιοποικιλότητας δίνουν ελάχιστη προσοχή στον μικροβιόκοσμο και πολλοί οργανισμοί διατήρησης των ειδών σε μεγάλο βαθμό δεν ενδιαφέρονται να επεκτείνουν το έργο τους στους μικροοργανισμούς.
Πρόσφατα, ο Αμερικανός Οικολόγος Κεντ Ρέντφορντ μέσω του περιοδικού Conservation Biology απηύθυνε έκκληση στους απανταχού οικολόγους να εστιάσουν στον μικροβιόκοσμο. Αγνοώντας τους μικροοργανισμούς, οι οικολόγοι αγνοούν το μεγαλύτερο μέρος της ζωής, αγνοούν αρχαίες και συναρπαστικές γενεαλογίες μικροοργανισμών που είναι πολύτιμες και απαραίτητες για κάθε είδους «άνθηση» στη Γη.
Οι μικροοργανισμοί δεν εξαλείφονται μεν, αλλά…
Συνήθως η απειλή εξαφάνισης ενός μεμονωμένου μικροβιακού είδους ή υποείδους δεν προκαλεί ανησυχία. Στην πραγματικότητα οι μικροοργανισμοί δεν εξαλείφονται εύκολα επειδή είναι ασύλληπτα πολυάριθμοι, αναπαράγονται γρήγορα και μπορούν να ανταλλάσσουν γονίδια με τους γείτονές τους, ενώ συνήθως προσαρμόζονται άριστα στις περιβαλλοντικές αλλαγές. Υπάρχει γενικά ένας «λειτουργικός πλεονασμός» στον μικροβιακόκοσμο. Αν η ρύπανση ή η κλιματική αλλαγή ή ένα ζιζανιοκτόνο εξαλείψει ένα είδος βακτηρίων που διακινεί θρεπτικά συστατικά ή άνθρακα με σημαντικό τρόπο στη φύση, υπάρχουν συχνά εκατοντάδες άλλοι τύποι βακτηρίων που κάνουν το ίδιο.
Για αυτό και η ανησυχία του Κεντ Ρέντφορντ δεν είναι τόσο η εξαφάνιση αυτή καθαυτή των μικροοργανισμών εξαιτίας της κλιματικής αλλαγής ή της σύγχρονης γεωργίας, αλλά η ριζική μεταλλαγή των μικροβιακών κοινοτήτων που επιφέρει δύσκολα προβλέψιμες συνέπειες για ένα πλήθος οικοσυστημάτων. «Για παράδειγμα, τα αυγά της άγριας πέστροφας καλύπτονται από ένα πολύπλοκο μείγμα βακτηρίων που μπορεί να προέρχονται από περισσότερες από δώδεκα διαφορετικές οικογένειες. Η αύξηση της θερμοκρασίας του νερού των ρεμάτων λόγω της κλιματικής αλλαγής μπορεί να αλλάξει ριζικά τους τύπους βακτηρίων που ζουν στα αυγά ή να τους αναδιατάξει. Και η νέα βακτηριακή κοινότητα που θα προκύψει μπορεί να είναι τοξική όχι μόνο για τα αυγά της πέστροφας, αλλά και για την ίδια», περιγράφει ο καθηγητής από την Σχολή Γεωπονικών Επιστημών του Πανεπιστημίου Θεσσαλίας, κ. Κωνσταντίνος Κορμάς. Σύμφωνα με μελέτες της ομάδας του καθηγητή που διερευνά τα μικροβιώματα των ψαριών, οι βακτηριακές κοινότητες του εντέρου μιας οργανικά εκτρεφόμενης τσιπούρας μοιάζουν περισσότερο με της άγριας, ενώ οι τσιπούρες που εκτρέφονται με τον συμβατικό τρόπο εμφανίζουν ένα πολύ διαφορετικής σύστασης εντερομικροβίωμα.
Unsplash
Σε ένα άλλο παράδειγμα, πολλές μετατοπίσεις ή επανεισαγωγές ειδών που γίνονται στο όνομα της διατήρησης αποτυγχάνουν και αυτό μπορεί να οφείλεται στο ότι δε λαμβάνεται υπόψη το μικροβιακό πλαίσιο. Μελέτες έχουν δείξει ότι τα ζώα σε αιχμαλωσία διαθέτουν συχνά πολύ διαφορετικά μικροβιώματα από τα άγρια ζώα του ίδιου είδους. Αν για παράδειγμα κάποιος μετακινήσει μια ζέβρα από έναν ζωολογικό κήπο στο Παρίσι στο Εθνικό Πάρκο Σερενγκέτι, στην Τανζανία, το ζώο μπορεί να αρρωστήσει ή στην καλύτερη των περιπτώσεων να μην απορροφήσει τα απαραίτητα συστατικά από την τροφή του, και αυτό γιατί ενώ διατηρούσε ένα μικροβίωμα κατάλληλο για την κατανάλωση του σανού του ζωολογικού κήπου του Παρισιού, ξαφνικά, το μικροβίωμά του κλήθηκε να αφομοιώσει τα χόρτα του Σερενγκέτι. «Η σημασία του μικροβιώματος κρίνεται κρίσιμη κυρίως κατά την περίθαλψη προστατευόμενων ζώων, όπως η Μεσογειακή φώκια, σύμφωνα με μια συνεχιζόμενη μελέτη από την ομάδα μας», συμπληρώνει ο καθηγητής Κορμάς.
Και τα φυτά διαθέτουν επίσης ένα μικροβίωμα και πολλά, για να απορροφήσουν θρεπτικά συστατικά και νερό, βασίζονται εν μέρει σε μύκητες που ζουν μέσα στις ρίζες τους. Αν μεταφυτευτούν χωρίς τους κατάλληλους μύκητες στη ρίζα είναι πολύ πιο πιθανό να πεθάνουν μετά τη φύτευση. Ερευνητές που εργάζονται για την αποκατάσταση λιβαδιών στην Ιντιάνα των ΗΠΑ διαπίστωσαν ότι η εισαγωγή των σωστών μυκήτων κατά την αποκατάσταση βιοτόπων αυξάνει την ποικιλότητα των φυτών κατά περίπου 70%. Ακόμη και η επικοινωνία μεταξύ των φυτών αποδίδεται σε διεργασίες όπου διαμεσολαβούν μικροοργανισμοί.
Δύσκολη η μελέτη των μικροοργανισμών
Η μελέτη των μικροοργανισμών χαρακτηρίζεται δύσκολη από τους επιστήμονες για πολλούς λόγους, με πρώτον ότι το είδος ορίζεται δύσκολα σε αυτούς. Τα βακτήρια, τα πρώτιστα, οι ιοί και άλλα μικροσκοπικοί οργανισμοί συχνά ανήκουν σε είδη που δεν μπορούν να διακριθούν εύκολα, εξελίσσονται γρήγορα, υβριδοποιούνται εύκολα, και ανταλλάσσουν γονίδια με άλλα είδη! Μερικές φορές ζουν οργανωμένοι σε βιοφίλμ, συνδέονται φυσικά, επικοινωνούν μεταξύ τους και λειτουργούν σχεδόν σαν ένας ενιαίος οργανισμός. Οι οικολόγοι αδυνατούν να μετρήσουν ή να κάνουν λίστες με απειλούμενα είδη μικροοργανισμών.
Επιπλέον-αν και οι πρόσφατες τεχνολογικές εξελίξεις το αλλάζουν αυτό-οι μικροοργανισμοί μετριούνται δύσκολα με τις παραδοσιακές μεθόδους (δεν μπορούν π.χ. να παρατηρηθούν μέσω δορυφόρου), γεγονός που τους «πετάει» ακόμη πιο έξω από τη ζώνη άνεσης της παραδοσιακής διατήρησης. Τέλος, οι προσπάθειες διατήρησης σε όλες τις κλίμακες δεν εξασφαλίζουν επαρκείς πόρους, επομένως υπάρχει κατανοητή απροθυμία για την εστίαση της έρευνας στη μικροβιακή ποικιλότητα χωρίς χρηματοδότηση.
Η βιολογική διατήρηση γενικά απομακρύνεται από την απλή αποκατάσταση και από την παροχή βοήθειας στα δυναμικά οικοσυστήματα για να προσαρμοστούν στις μεταβαλλόμενες συνθήκες και εστιάζει στο πως επηρεάζεται η τροχιά των μικροβιακών κοινοτήτων ή στην ενσωμάτωση τροποποιημένων μικροοργανισμών στα οικοσυστήματα. Οι μονάδες επεξεργασίας λυμάτων χρησιμοποιούν ήδη διάφορες κοινότητες βακτηρίων, Αρχαίων και πρωτόζωων για τον καθαρισμό του νερού, ακόμη και για τη μετατροπή των λυμάτων σε βιοπλαστικό. Μια πρόσφατη μελέτη εντόπισε ήδη ένα βακτήριο που μπορεί πραγματικά να διασπάσει εντελώς το πλαστικό, το οποίο μπορεί να αποτελέσει μια στρατηγική διατήρησης στο μέλλον.
































